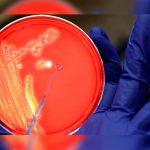

Etiqueta: antibioticos
Nueva molécula abre la vía para acabar con resistencia de superbacterias
Madrid, 2 nov (EFE).- La resistencia de las bacterias a los antibióticos es un problema de salud mundial cada vez más grave y uno...
Este centenario ‘devorador de bacterias’ podría ‘jubilar’ a los antibióticos
El fenómeno de la resistencia de las bacterias a ciertos tipos de antibióticos se ha convertido en una creciente amenaza en todo el mundo,...
Nanotecnología para superar la resistencia a los antibióticos
Madrid, 4 oct (EFE).- El uso de nanopartículas activadas por la luz -llamadas puntos cuánticos- puede dar un impulso crucial a la eficacia de...
Alarmante: la escasez de antibióticos preocupa a la OMS
La OMS se alarmó este miércoles de la "seria escasez" de nuevos antibióticos en desarrollo para combatir las bacterias cada vez más resistentes, y...
Dar antibióticos a la madre en el parto afecta a la flora intestinal del...
Madrid, 16 ago (EFE).- La administración de antibióticos a la madre durante el parto es una práctica común que se prescribe en el 30...
La grave enfermedad sexual de los amantes del sexo oral
El sexo oral está contribuyendo a la aparición de un peligroso tipo de gonorrea resistente a los antibióticos, pero además, una caída en el...
OMS alertó propagación de gonorrea resistente a antibióticos
Los nuevos cepos serían resistentes a los antibióticos. La Organización Mundial de Salud calcula que 78 millones de personas por año padecen la enfermedad...
Cuáles son las nuevas categorías de antibióticos creadas por la OMS
La Organización Mundial de la Salud presentó este martes una nueva división de los antibióticos, en la que diferenció los que deben usarse para...
OMS pide mejorar la higiene de manos para prevenir más infecciones
La Organización Mundial de la Salud (OMS) hace un llamamiento a todos los países y centros de salud para fortalecer los programas de prevención...
Descubren la auténtica causa del acné
La mayoría de nosotros entre el 80 y el 85% para ser exactos, hemos sufrido acné en algún momento de nuestras vidas. Más de uno...